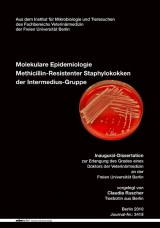
Molekulare Epidemiologie Methicillin-Resistenter Staphylokokken der Intermedius-Gruppe - Claudia Ruscher

Molekulare Epidemiologie Methicillin-Resistenter Staphylokokken der Intermedius-Gruppe
Seiten
2010
Mensch & Buch (Verlag)
978-3-86664-860-9 (ISBN)
Mensch & Buch (Verlag)
978-3-86664-860-9 (ISBN)
- Titel ist leider vergriffen;
keine Neuauflage - Artikel merken
| Sprache | deutsch |
|---|---|
| Einbandart | gebunden |
| Themenwelt | Veterinärmedizin |
| ISBN-10 | 3-86664-860-X / 386664860X |
| ISBN-13 | 978-3-86664-860-9 / 9783866648609 |
| Zustand | Neuware |
| Informationen gemäß Produktsicherheitsverordnung (GPSR) | |
| Haben Sie eine Frage zum Produkt? |
Mehr entdecken
aus dem Bereich
aus dem Bereich
Ein Handbuch für Tiermedizinische Fachangestellte
Buch | Softcover (2025)
Lehmanns Media (Verlag)
CHF 23,70
Buch | Hardcover (2025)
Schlütersche (Verlag)
CHF 124,60
Buch | Hardcover (2025)
John Wiley & Sons Inc (Verlag)
CHF 319,95